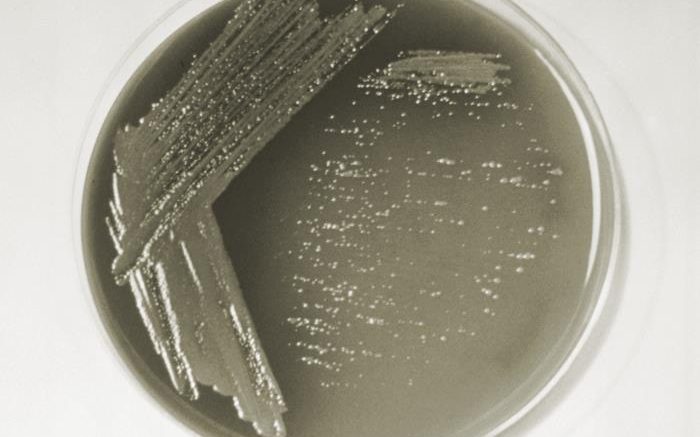

Preliminary results of a nationwide study suggest that the disinfectant used to treat water before it is distributed through pipes may impact the incidence of Legionnaire’s disease in certain parts of the country. The findings will be presented Dec. 9 at the annual meeting of the Society for Risk Analysis in Washington, D.C.
Waterborne diseases – caused by bacteria, viruses, and parasites – affect more than 7 million people in the United States every year, according to the Centers for Disease Control (CDC). One of them is Legionnaires’ disease, a potentially severe pneumonia. It is caused by the bacterium Legionella, which grows in the pipes of water systems, where it can be spread through aerosolized droplets from sources such as showerheads, decorative fountains, or building cooling towers.
Researchers conducted an epidemiological study comparing historical data on Legionnaire’s disease in the United States with 25 water utilities’ treatment attributes (representing all 10 EPA regions). The rates of Legionnaires’ disease among residents served by the utilities in the study ranged from no reported cases to an average of 8.36 cases per 100,000 people.
Preliminary findings show that:
- There are higher rates of Legionnaires' Disease in zip codes served by water treatment plants that use chlorine as the primary disinfectant, rather than monochloramine.
- There are also higher rates of disease when plants use chlorine as the secondary disinfectant, rather than using chlorine as the primary disinfectant and monochloramine as the secondary disinfectant.
- There was a seasonality result in the data, with Legionnaires' disease occurring less frequently in the winter months and most frequently in the summer months.
These preliminary results back up data from previous studies of individual buildings. (For example, previous research has found that in healthcare facilities where the water is treated with monochloramine, there is a lower prevalence of Legionnaires’ disease.) The risk for Legionnaires' disease is higher for people with weakened immune systems, older adults, smokers, and those with chronic lung or kidney diseases.
“Legionella is extremely challenging to treat and manage in a building’s plumbing system once it establishes a niche,” says Alexis Mraz, author of the study and an assistant professor of public health at The College of New Jersey. “It is important to think about the whole life of the water, from treatment to tap, when we consider how to best manage this pathogen and lower the incidence of Legionnaires’ disease.”
Source: Society for Risk Analysis (SRA)